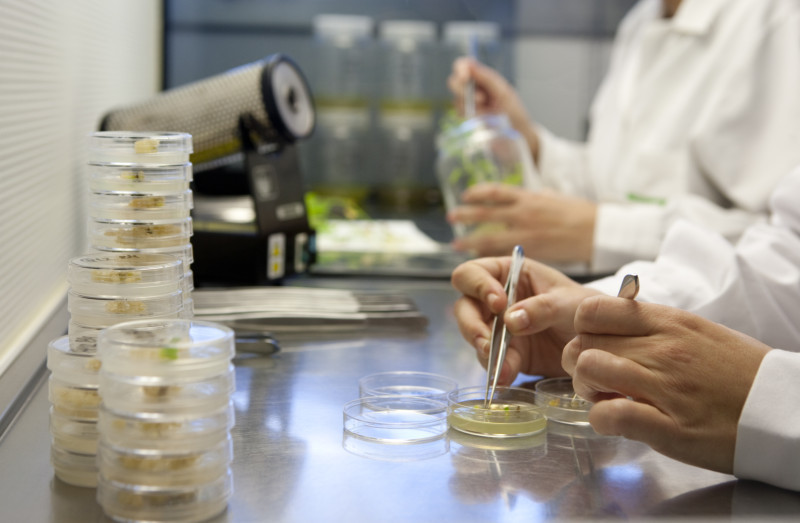

НОВОСТИ
СВЯЗАТЬСЯ С НАМИ
Ознакомьтесь с нашей дистрибьюторской сетью по всему миру
Центральный офис
Узбекистан, Ташкент, 100017, Юнусабадский р-н, м-в Кашгар (Ц-4),ул. А. Кадыри, дом 25
☎ +998903706057 Азиз Махкамов
Telegram: https://t.me/fitouz
Instagram: https://www.instagram.com/SemillasFitoCentralAsia
Facebook: https://www.facebook.com/SemillasFitoCentralAsia
YouTube: https://www.youtube.com/user/SemillasFitoTV/videos